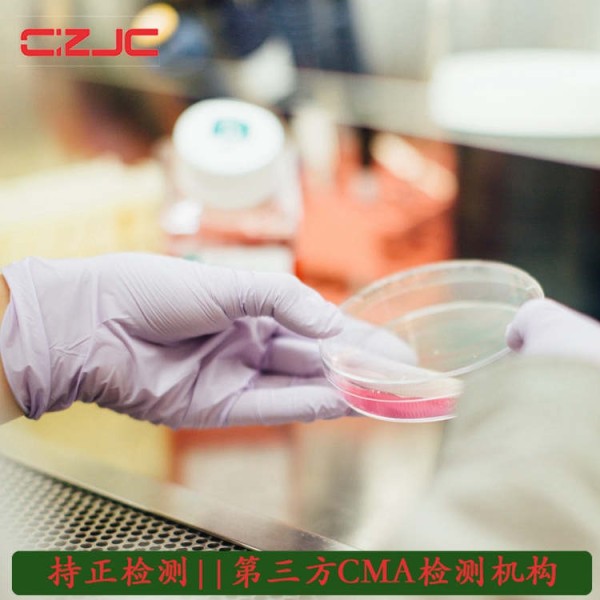
吉林省一次性清洁用品检测检测第三方--持正检测

吉林省一次性清洁用品检测检测第三方
找专业的第三方检测机构进行深度检测,以保证公正性。 #生活技巧# #汽车保养技巧# #二手车检测技巧#
吉林省一次性清洁用品检测检测第三方--持正检测 近年来,随着国内居民生活水平的提高,对于一次性使用卫生用品的需求也出现大幅增长,特别是儿童消费热持续升温和老龄人口不断增加,以儿童纸尿裤、成人尿布等产品为代表的进口一次性使用卫生用品出现持续快速增长。

纸巾测试:亮度、可迁移性荧光增白剂、灰分、洞眼、尘埃度、水分、内装量、尺寸、偏斜度、外观质量、细菌菌落数、大肠菌群。卫生纸:亮度、洞眼、尘埃度、水分、偏斜度、尺寸偏差、细菌菌落数、大肠菌群。一次性使用卫生用品:细菌菌落数、大肠菌群。卫生巾:偏差、吸水倍率、pH、水分、细菌菌落数、大肠菌群。
一次性清洁用品检测 一次性使用卫生用品是指使用-次后即丢弃的,与人体直接或间接接触的,并为达到人体生理卫生或卫生保或指套(不包括医用手套或指套)、纸巾、湿巾、卫生湿巾、卫生棉(棒、签、球)、化妆棉(纸、巾)、纸质餐饮具、膜、帽子、口罩、内裤、妇女经期卫生用品(包括卫生护垫)、尿布等排泄物卫生用品(不包括皱- .次性使用卫生用品是指使用-次后即丢弃的,与人体直接或间接接触的,并为达到人体生理卫生或卫生保 健(抗菌或抑菌)目的而使用的各种日常生活用品,产品性状可以是固体也可以是液体。例如,一次性使用手套 或指套(不包括医用手套或指套)、纸巾、湿巾、卫生湿巾、卫生棉(棒、签、球)、化妆棉(纸、巾)、纸质 餐饮具、膜、帽子、口罩、内裤、妇女经期卫生用品(包括卫生护垫)、尿布等排泄物卫生用品(不包括皱 纹卫生纸等厕所用纸)、避孕套等,以及卫生部所发布的其他一次性使用卫生用品。

消毒效果生物监测评价:环氧乙烷消毒杀菌:对枯草杆菌灰黑色变异芽胞(ATCC 9372)的消灭实验 电磁波辐射消毒杀菌:对短小精悍链球菌芽胞E6d(ATCC27142)的消灭实验 工作压力蒸气消毒杀菌:对嗜热人体脂肪链球菌(ATCC 7953)的消灭试验。

一次性清洁用品检测 一次性使用卫生用品是指使用一次后即丢弃的,与人体直接或间接接触的,并为达到人体生理卫生或卫生保健(**或抑菌)目的而使用的各种日常生活用品,产品性状可以是固体也可以是液体。例如,一次性使用手套或指套(不包括医用手套或指套)、纸巾、湿巾、卫生湿巾、卫生棉(棒、签、球)、化妆棉(纸、巾)、纸质餐饮具、膜、帽子、口罩、内裤、妇女经期卫生用品(包括卫生护垫)、尿布等排泄物卫生用品(不包括皱纹卫生纸等厕所用纸)、避孕套等,以及卫生部所发布的其他一次性使用卫生用品。
一次性使用卫生用品检测范围:一次性注射器、一次性输液器、一次性口罩、一次性帽子、一次性手套、一次性鞋套、一次性手术衣、一次性手术器械、一次性手术单、一次性床单、一次性被套、一次性器械套、一次性手术包、一次性麻醉包、一次性穿刺包等。
持正检测(山东)有限公司*遵守相关法律法规的规定,(dsfzpz2211)坚持立足山东、服务的发展战略,旨在打造国内*的综合性检测与评价服务机构。本着“科学、公正、准确、高效、合理、满意”的服务理念,努力把公司建设为我国生物安全、洁净检测领域的“领航者”。
网址:吉林省一次性清洁用品检测检测第三方 https://www.yuejiaxmz.com/news/view/1451425
相关内容
外卖行业一次性清洁用品检测检测第三方公司陕西省一次性清洁用品检测检测公司
江西省一次性清洁用品检测
一次性清洁巾检测报告在哪可以办理?—企检网
佛山市食品营养标签检测,第三方检测机构
聊城市食品厂洁净室空气洁净度检测第三方检测费用
二手物品第三方检测平台
地毯清洗剂第三方检测机构:地毯清洗剂检测有哪些项目
佛山市个人护理卫生用品测试,日用品检测,化妆品检测
北京检测公司,北京第三方检测机构,生活饮用水检测机构,空调检测,餐饮油烟检测,空气质量检测,污水检测,北京中天云测

